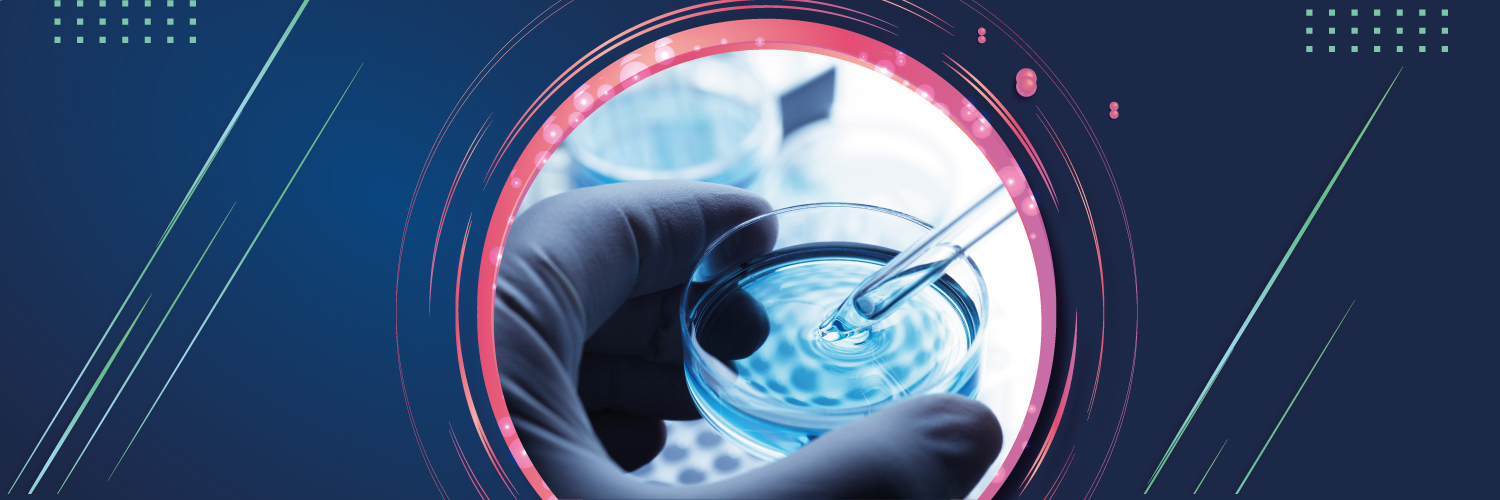
Sheba Research Authority banner

📢📢📢Exciting News!
We are very excited to share the publication of the groundbreaking research led by Dr. @TomItkin from @sheba_medical and @TelAvivUni in @Nature Immunology. 👏
Collaborated with @Cornell @MountSinaiNYC @MSKCancerCenter and others.
➡️nature.com/articles/s4159…


English